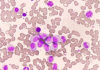
Bexobrutideg Produces Rapid and Durable Responses in CLL

AMCP ASH 2025
The 67th American Society of Hematology (ASH) Annual Meeting and Exposition will take place December 6-9, 2025, in Orlando, Florida, and online. The meeting is the world’s most comprehensive hematology event of the year, featuring hundreds of sessions and thousands of abstracts.
Day 1
Day 2
Day 3
Advertisement